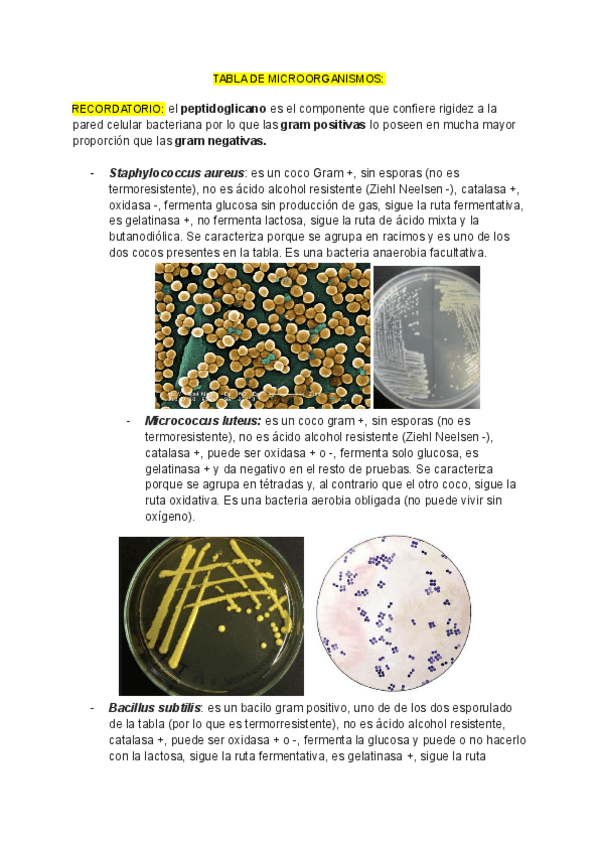

@biotec__
25 Publicaciones
812 Interacciones
0 Seguidores
0 Siguiendo
Lista de publicaciones de biotec__
He publicado nuevos examenes de 1º Microbiología: Documento-sin-titulo.pdf
He publicado nuevos apuntes de 1º Química Orgánica: Documento-sin-titulo.pdf
ejercicios
-
Ejercicios asignados tema 3
He publicado nuevos ejercicios de 1º Química Orgánica: Ejercicios asignados tema 3
ejercicios
-
Actividades tema 2
He publicado nuevos ejercicios de 1º Química Orgánica: Actividades tema 2
He publicado nuevos ejercicios de 1º Química Orgánica: Documento-sin-titulo.pdf
ejercicios
-
Seguimiento hoja 3
He publicado nuevos ejercicios de 1º Química Orgánica: Seguimiento hoja 3
He publicado nuevos ejercicios de 1º Química Orgánica: tema-4-quimica-organica.pdf
ejercicios
-
Actividades tema 3
He publicado nuevos ejercicios de 1º Química Orgánica: Actividades tema 3
ejercicios
-
Actividades tema 3
He publicado nuevos ejercicios de 1º Química Orgánica: Actividades tema 3
He publicado nuevos ejercicios de 1º Química Orgánica: Quimica-organica-tema-1-2.pdf